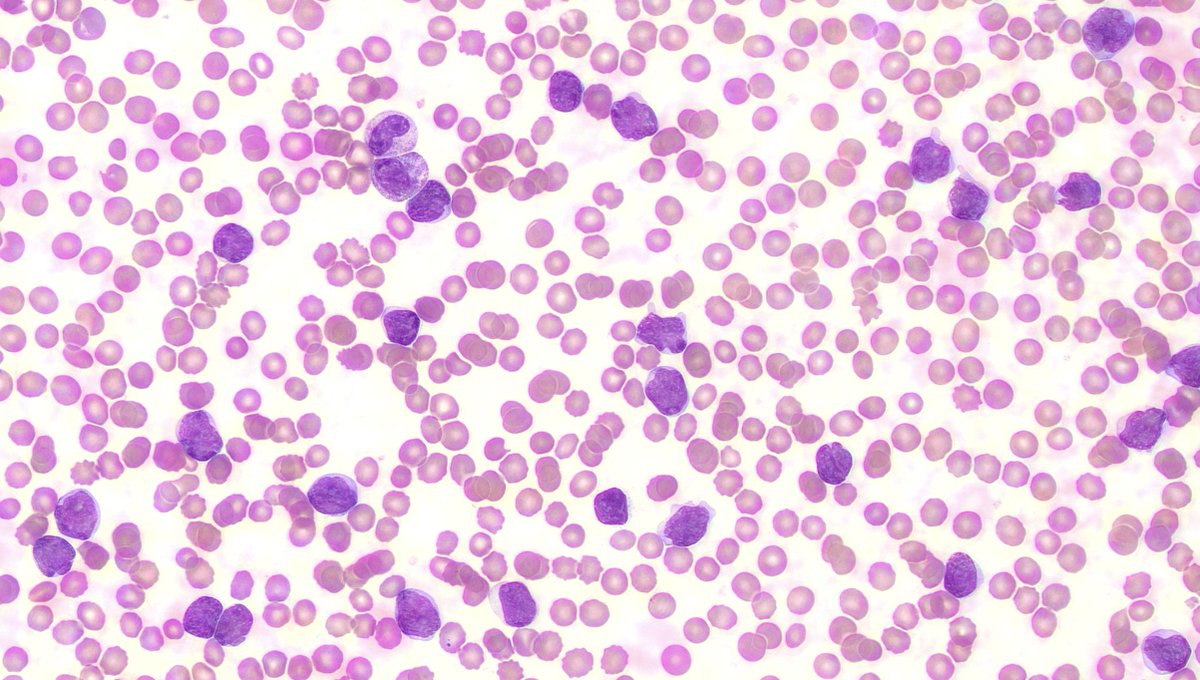

Sibel AK, MD
@sibelak_md
Chief Resident, PGY-3 Pathology @UTHoustonPath| Former Postdoc Assoc @BCMHouston| Interested in #hemepath #molecular
ID: 1443246157388521482
29-09-2021 16:08:19
445 Tweet
423 Takipçi
243 Takip Edilen

With the mentoring (and financial) support provided by UTHealth Houston Pathology, our residents enjoy participating in many meetings during their training, as seen at #CAP24! Great job y'all! 👏🔬#PathMatch2025 #pathX


I had an amazing time at #CAP24! It was great reconnecting with old friends, meeting new colleagues, attending outstanding sessions, and enjoying the vibrant atmosphere of #LasVegas. Hope to meet again at #CAP25🤗 #Pathtwitter UTHealth Houston Pathology #Pathology



Hello #PathTwitter #PathX! I need you to please send this survey to EVERY M3, M4, or PGY1 that you know! luc.co1.qualtrics.com/jfe/form/SV_0S… It takes a few minutes to complete and will give us important data regarding medical education. Inside The Match MatchToPath

Last call for voting in the UTHealth Houston Pathology #PathArt Contest! Head over to UTHealth Houston Pathology to check out the entries and vote for your favorite!

Head over to UTHealth Houston Pathology to see entries and vote in this years Resident #PathArt contest!


Congratulations! Well deserved Amanda Herrmann MD, PhD 🎉



Honored and grateful to be selected as Chief Resident in my residency program! Thrilled to work alongside the talented and dedicated Dr. Abu Qubo’. Excited to continue to give back to such an incredible team. Let’s inspire, learn, and grow! UTHealth Houston Pathology Ahmad Abu Qubo #PathTwitter




Happy New Year from UTHealth Houston Pathology! Wishing you all the best in the coming year! #PathX #PathTwitter #MatchtoPath #NewYear2025 🎆🎇

Please join Lymphoma Unknown Conference by Dr. Medeiros @4PM CT Fri 1/23. Cases below. Preview Link: pathpresenter.net/public/present… Meeting Link: mdacc.zoom.us/j/81492289011?… #hemepath #pathedu #pathtwitter SHUYU E MD, PhD PaulYoungMD Sanam Loghavi, MD صنم لغوی 🔬🧬 Siba El Hussein, MD


On 2/18/25 #UTHoustonPath will host the Citywide Surgical Pathology Conference with learners from programs across Texas Medical Center presenting interesting cases. If you are in Houston, join us in McGovern Med School MSB 2.103 at 5:30 PM. Houston Methodist Pathology & Genomic Medicine BCM_PathRes #pathX #PathTwitter